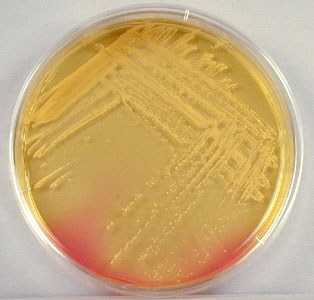

Как лечить стафилококк в горле – как избавиться от инфекции 2019
Стафилококками называют факультативно-анаэробные бактерии, которые могут провоцировать развитие тонзиллита, ларингита, пневмонии, ринита, синусита, фарингита и т.д. Микроорганизмы проявляют свою патогенность, т.е. болезнетворность, исключительно при воздействии провоцирующих факторов – железодефицитная анемия, авитаминоз, переохлаждение, дисбактериоз или обострение хронических заболеваний.Содержание статьи
 Как лечить стафилококк в горле? Не все знают, что полностью уничтожить стафилококков в организме нельзя, так как некоторые штаммы бактерий являются «нормальными» представителями микрофлоры слизистых дыхательных путей.
Как лечить стафилококк в горле? Не все знают, что полностью уничтожить стафилококков в организме нельзя, так как некоторые штаммы бактерий являются «нормальными» представителями микрофлоры слизистых дыхательных путей.
Болезнь развивается только в том случае, если количество микробов резко увеличивается.
Чтобы снизить концентрацию патогенов в организме, необходимо принимать лекарства антистафилококкового, иммуностимулирующего и противомикробного действия.
Принципы лечения
Какими аптечными средствами нужно лечить золотистый стафилококк в горле? Золотистый стафилококк – один из самых опасных штаммов бактерий, который обладает устойчивостью к большинству антибиотиков. Он выделяет особые ферменты, которые нейтрализуют действие противомикробных средств. Поэтому для уничтожения микробов используют антистафилококковые лекарства – иммуноглобулины, анатоксины, бактериофаги и т.д.
Основными целями терапии стафилококковой инфекции являются:
- подавление активности возбудителей инфекции;
- восстановление целостности пораженных слизистых;
- повышение общего и местного иммунитета.
Неосложненные формы ЛОР-заболеваний можно вылечить с помощью местных антибиотиков, но если стафилококковая инфекция распространилась за пределы горла и поразила нижние дыхательные пути, в схему терапии включают системные антибиотики и сильнодействующие антистафилококковые препараты.
На этапе разрешения воспалительных реакций больному может быть назначен курс физиотерапевтических процедур. Прохождение УФ-терапии позволяет нормализовать окислительно-восстановительные процессы в тканях, повысить местный иммунитет и уничтожить патогенную микрофлору в дыхательных путях.
Системные антибиотики
В большинстве случаев лечение стафилококка в горле сопровождается приемом антимикробных препаратов системного действия. Они выпускаются в форме таблеток, сиропов, суспензий или инъекционных растворов. Антибактериальная терапия предназначена для лечения хронических воспалений горла и заболеваний, спровоцированных золотистым стафилококком. Именно этот штамм бактерий выделяет наибольшее количество токсических веществ, которые негативно влияют на работу сердца, почек, печени, легких и даже мозга.
Чтобы уничтожить микробов в органах дыхания, назначают только те антибиотики, которые обладают устойчивостью к действию пенициллиназы и бета-лактамазы. Специфические ферменты, которые синтезируются стафилококками, инактивируют «простые» антибиотики пенициллинового ряда. Поэтому их не используют в терапии стафилококковых инфекций.
Как правило, в схему антибактериального лечения включают такие медикаменты:
| Группа препаратов | Наименования препаратов | Принцип действия |
|---|---|---|
| макролидные | «Эритромицин» | угнетает размножение микробов за счет разрушения пептидных связей |
| «Кларитромицин» | препятствует синтезу белков, вследствие чего нарушается репродуктивная функция бактерий | |
| препараты бета-лактамного ряда | «Цефалексин» | разрушает клеточные стенки стафилококков, что приводит к их гибели |
| «Цефотаксим» | препятствует биосинтезу белков, вследствие чего нарушается продукция дочерних клеток микробов | |
| «Оксациллин» | предупреждает репликацию днк в бактериях, за счет чего уменьшается количество патогенов в очагах поражения | |
| линкозамиды | «Нелорен» | уничтожает грамположительные бактерии за счет разрушения их клеточных структур – рибосом, мембран. |
| «Клиндамицин» | ингибирует биосинтез микробных рибосом, что препятствует образованию клеточных структур патогенов |
Важно! Неадекватный прием антибиотиков может стать причиной мутации стафилококков и возникновения у них устойчивости к действию препаратов.
Антистафилококковые препараты
Лечение золотистого стафилококка в горле заключается в применении сильнодействующих препаратов, уничтожающих микробы или стимулирующих формирование противостафилококкового иммунитета. В состав медикаментов входят обезвреженные бактерии, что стимулирует в организме выработку специфических антител. Для подавления стафилококковой инфекции применяются:
| Название препарата | Форма выпуска | Принцип действия |
|---|---|---|
| «Стафилококковый анатоксин» | ампулы для инъекций | стимулирует выработку специфического иммунитета против большинства штаммов стафилококков и их токсинов |
| «Стафилококковый антифагин» | ампулы для инъекций | повышает антимикробный иммунитет, что ускоряет процесс уничтожения болезнетворных микробов в организме |
| «Стафилофаг» | раствор для промывания и орошения ротоглотки | вымывает большинство бактерий из слизистых оболочек и повышает местный иммунитет |
| «Сектафаг» | сыворотка для инъекций | препятствует размножению стафилококков, стрептококков и других грамположительных микробов |
| «Интести-бактериофаг» | раствор для перорального приема | уничтожает бактерии в слизистых оболочках ЖКТ и органов дыхания, препятствует развитию дисбактериоза |
Большинство антистафилококковых лекарств обладают побочным действием, поэтому их используют преимущественно для лечения взрослых.
В состав лекарств входят токсические компоненты, которые создают нагрузку на печень и почки, поэтому их не рекомендуется использовать лицам, страдающим печеночной или почечной недостаточностью.
Растворы для полоскания горла
Как вылечить стафилококковую инфекцию в дыхательных путях? Медикаменты местного действия используют исключительно в рамках прохождения комплексной терапии. Они способствуют угнетению активности бактерий, однако не уничтожают их полностью. Чтобы уменьшить выраженность симптомов заболевания, рекомендуется проводить санацию горла.
Для промывания слизистой гортаноглотки используют растворы, которые обладают обеззараживающим действием. Они не только уничтожают часть микробов, но и способствуют уменьшению воспаления в местах локализации стафилококков. Антисептики широко применяются в педиатрической практике, так как они практически не содержат в себе токсических веществ и потому не вызывают побочных реакций:
| Наименование препарата | Форма выпуска | Принцип действия |
|---|---|---|
| «Хлорофиллипт» | уничтожает грамположительные бактерии, аденовирусы, риновирусы и дрожжеподобные грибки, уменьшает воспаление и отечность горла | стафилококковый тонзиллит, ларингит, бронхит, сепсис |
| «Мирамистин» | стимулирует активность иммунных клеток, за счет чего повышается местный иммунитет | гайморит, отит, ангина, фарингит, ларинготрахеит |
| «Тантум Верде» | обеззараживает слизистые и препятствует появлению гнойников в местах воспаления | глоссит, стоматит, острый тонзиллит, фарингит, гингивит |
| «Гексорал» | разрушает клетки патогенов и способствует восстановлению целостности слизистых гортаноглотки | афтозный стоматит, ларингит, стафилококковый тонзиллит, фарингит |
| «Хлоргексидин» | подавляет активность микробов и грибков, что препятствует появлению гнойно-воспалительных процессов | бактериальные инфекции ротовой полости и горла |
Чтобы предотвратить аллергические реакции, перед санацией горла антисептики нужно развести с водой в пропорциях, указанных в инструкции к применению лекарства.
Не рекомендуется пренебрегать местной терапией при развитии бактериального воспаления в слизистых органов дыхания. Антисептические растворы создают в горле неблагоприятные для размножения патогенов условия, что позволяет предотвратить развитие побочных заболеваний.
Леденцы для рассасывания
В состав пастилок и леденцов для рассасывания входят вещества, которые обладают обеззараживающим, противоотечным и противовоспалительным действием. Их использование позволяет уменьшить выраженность болевых ощущений в горле и предотвратить развитие стеноза. Лечение стафилококка в горле может осуществляться с помощью таких аптечных средств, как:
| Название пастилок и леденцов | Механизм действия | Противопоказания |
|---|---|---|
| «Декатилен» | уничтожает болезнетворные бактерии смешанной флоры, уменьшает воспаление и отечность | сахарный диабет |
| «Септолете» | устраняет кашель и воспалительные реакции в тканях гортаноглотки | гиперчувствительность к компонентам пастилок |
| «Фарингосепт» | ликвидирует воспаление и уничтожает грамположительные микробы, устраняет першение и боли при глотании | гастрит, дисбактериоз, сахарный диабет |
| «Фарингтон» | дезинфицирует слизистые и способствует выведению токсинов из пораженных тканей | беременность и лактация, панкреатит, язва желудка |
| «Граммидин» | уменьшает выраженность воспалительно-инфекционных реакций и повышает местный иммунитет | пищевой диатез, нарушения в работе органов ЖКТ |
После рассасывания пастилок нежелательно употреблять пищу и питье в течение 30-40 минут.
Систематическое применение леденцов и пастилок способствует накапливанию активных веществ препаратов в пораженных тканях. Это позволяет ускорить процесс уничтожения стафилококковой инфекции в горле и регенерацию воспалившихся участковых слизистых.
Растительные адаптогены
Растительные адаптогены (фитоадаптогены) – лекарства, которые повышают сопротивляемость организма болезнетворным вирусам, грибкам, бактериям, простейшим и т.д. В их состав входят микроэлементы и витамины, которые стимулируют неспецифический иммунитет, за счет чего снижается вероятность развития инфекционных заболеваний.
Каких результатов ждать от приема адаптогенов? Стафилококки выделяют токсические вещества, которые приводят к отравлению организма и появлению общих признаков интоксикации – отсутствие аппетита, хроническая усталость, апатия, быстрая утомляемость и т.д. Фитоадаптогены стимулируют биохимические процессы в организме, за счет чего существенно уменьшается выраженность симптомов интоксикации.
Регулярный прием растительных адаптогенов не только улучшает качество жизни больного, но и препятствует обострению бактериального воспаления в респираторном тракте. К числу самых действенных фитопрепаратов относят:
- лимонник;
- настойку эхинацеи;
- облепиху;
- розовую радиолу;
- аралию.
Нельзя принимать адаптогены пациентам, страдающим гипертензией, так как большинство из них способствуют повышению артериального давления.
Перед использованием фитосредств беременными женщинами и детьми желательно проконсультироваться с врачом. Переизбыток биологически активных веществ в организме может привести к побочным эффектам, появлению крапивницы, бессонницы, сильного зуда и отека слизистых.
Иммуномодуляторы
Иммуномодуляторы – препараты растительного или животного происхождения, которые оказывают регулирующее действие на иммунную систему человека. При обнаружении стафилококков в дыхательных путях больному могут назначаться лекарства, стимулирующие в организме выработку иммуноглобулинов. Иммуностимулирующая терапия не только предотвращает рецидивы заболевания, но и препятствует прогрессированию уже существующего бактериального воспаления в горле.
Для подавления активности стафилококковой флоры в ЛОР-органах могут применяться следующие иммуностимуляторы:
- «Полудан»;
- «Рибомунил»;
- «ИРС-19»;
- «Тактивин».
Лекарства рекомендуется принимать не только во время обострения инфекционных заболеваний, но и в течение месяца после исчезновения симптомов воспаления горла. Иммуностимуляторы в обязательном порядке должны приниматься пациентами, страдающими вторичными иммунодефицитами.
Лечение стафилококкового носительства
Как вылечить золотистого стафилококка? Золотистый стафилококк – самый грозный представитель кокковых бактерий, развитие которого влечет за собой тяжелые системные осложнения. Он выделяет токсины, которые могут накапливаться в почках, сердце, суставах и других органах, вызывая тяжелые заболевания.
Для уничтожения в организме золотистого стафилококка может использоваться следующая схема лечения:
- закапывание «Стафилококкового бактериофага» в нос на протяжении 7-10 дней по 3-4 мл в каждую ноздрю;
- прием «Бронхо-мунала» по 1 капсуле в день натощак на протяжении месяца;
- впрыскивание по 2 дозы «ИРС-19» в каждую ноздрю дважды в сутки на протяжении 10 дней.
Примерно через месяц после прохождения терапии нужно сделать контрольный посев на микрофлору. При отсутствии золотистого стафилококка в организме пациенту назначают прием иммуностимулирующих средств. Если же носительство бактерий сохраняется, желательно провести вакцинацию анатоксином.
Автор: Гусейнова Ирада
Источники: medscape.com, health.harvard.edu, medicalnewstoday.com.
basket-parts.ru
Золотистый стафилококк в горле: причины и лечение (фото)
Золотистый стафилококк — представитель условно-патогенной флоры. Обитает в человеческом организме почти с рождения ввиду высокой степени вирулентности (способности поражать потенциального носителя).
Определяется как пиогенный (гноеродный) грамположительный микроорганизм аэробного типа (требуется кислород для жизнедеятельности). Распространенность патогенной структуры широка: как показывает медицинская статистика, инфицирован почти каждый или около 98% людей в популяции.
Золотистый стафилококк легко передается от человека к человеку. Обнаруживается в окружающей среде, на предметах обихода, на продуктах питания, в слизистом секрете человеческого организма и т.д.
Свое название организм получил благодаря схожести с гроздью винограда (staphyle означает гроздь). Бактерия имеет шарообразную форму и лишена способности передвигаться. Никаких органелл для транспортировки не предусмотрено.
Несмотря на отсутствие способности к движению, это крайне опасный организм, который провоцирует разнообразные заболевания отоларингологического, пульмонологического и иного профиля.
Об опасностях поражения горла стафилококком

Горло человека, как и ротоглотка в целом сталкивается со стафилококком в первую очередь (почему так — описано ниже). Описанная патогенная структура заразна, провоцирует опасные для жизни и здоровья болезни, вроде ангин (тонзиллитов), фарингитов, ларингитов.
При нисходящем пути транспортировки инфекции возможны более сложные поражения организма, в том числе нижних дыхательных путей (пневмонии, бронхиты).
Опасности подобного соседства множественны:
- Во-первых, микроорганизм устойчив к большинству антисептических препаратов. Наблюдается подобное по причине создания крупных конгломератов себе подобных. При воздействии лекарственного препарата поражается лишь верхний слой кокков, нижние же остаются нетронутыми и продолжают активную репликацию (размножение).
- Стафилококк продуцирует эндотоксины. При обширных поражениях горла это ведет к отравлениям. Если же бактерии находятся в латентной, спящей фазе, высока вероятность развития гастритов, рефлюкс-эзофагитов и язв желудка (не стоит заблуждаться, гастрит далеко не всегда провоцируется хиликобактер пилори).
- Наконец, микроорганизм синтезирует липазу и пенициллиназу. Это особые ферментативные вещества. Первое помогает расплавлять кожные покровы и слизистые, проникать все глубже и глубже в анатомические структуры, второе вещество делает золотистый стафилококк в горле невосприимчивым к пенициллинам и некоторым другим антибактериальным средствам.
Все это делает столь ничтожную на первый взгляд бактерию серьезнейшим противником. Лечение стафилококка в горле возможно только под контролем специалиста, но и этого недостаточно.
Требуется постоянно следить за лабораторными показателями (общим анализом крови, бактериологическим анализом слизистого отделяемого глотки и носа).
Причины возникновения стафилококка у человека
Как правило, речь идет о двух группах факторов. Первый фактор — это проникновение в организм патогенных микроорганизмов.

Учитывая высокую вирулентность золотистого стафилококка, присутствие агента в глотке — почти гарантированный факт.
Второй весомый фактор — снижение интенсивности работы иммунной системы и приобретение иммунодефицита (вне связи этого термина с одноименным вирусом, в этом случае требуется широкая трактовка).
Почему же снижаются защитные силы организма человека:
- Прием антибиотиков. Особенно бесконтрольный. Принимая столь опасные для жизни и здоровья препараты, пациент рискует на корню угробить иммунную систему с туманными перспективами восстановления защитных функций тела. Особенно опасны фторхинолоны и макролиды. Это препараты «тяжелой артиллерии». Они назначаются в крайних случаях.
- Употребление гормональных препаратов. Как правило, речь идет о представительницах слабого пола, которые пьют оральные контрацептивы на основе синтетических заместителей эстрогена. Подобные лекарства принимают только по назначению специалиста.
- Стрессовые ситуации, избыточные физические нагрузки. Вызывают чрезмерный синтез гормонов коры надпочечников. Адреналин, норадреналин, кортизол. Кортикостероиды угнетают выработку Т-лимфоцитов и лейкоцитов (иммунных клеток).
- Авитаминоз, гиповитаминоз, спровоцированный алиментарными факторами. Неправильное или недостаточное питание — фактор риска становления стафилококка в носу и горле, а также на дермальных покровах.
- Дисбактериоз кишечных структур. Это дисбаланс кишечной флоры, когда условно-патогенные и патогенные микроорганизмы превалируют над полезными. Встречается подобное чаще всего у детей или у больных людей. Сказываются патологии эндокринной сферы, сердечнососудистой системы и др.
- Наличие в анамнезе инфекционных очагов. Они «перетягивают внимание» иммунитета на себя. В итоге защитная система не может адекватно среагировать на наступающую угрозу.
- Переохлаждения.
- Злоупотребление алкоголем.
- Употребление цитостатиков в рамках химиотерапии при онкологии.
- Частые острые респираторные вирусные инфекции.
Причины развития стафилококковой инфекции у детей
- Недоношенность ребенка.
Также сказывается на работе его иммунитета. При рождении у детей с недостаточной массой тела защитная система практически не работает, что вынуждает помещать подобных маленьких пациентов в «тепличные» условия.
- Позднее прикладывание к молочным железам, если речь идет о грудном ребенке.
Как показывает практика, многие младенцы (почти четверть всей популяции на Земле) страдают заболеваниями носоглотки. Почти всегда эти болезни провоцируются стафилококком золотистого типа.
Позднее прикладывание груди играет в этом не последнюю роль. Дело в том, что материнское молоко требуется новорожденному с первых же дней жизни. Причина — необходимость получения важных иммуностимулирующих веществ. Они в своем роде уникальны и по концентрации, и по качеству.
Потому матерям можно дать совет — прикладывать младенца к груди как можно раньше. Это повысит резистентность структур организма ко всей патогенной и условно-патогенной флоре.
- Искусственное вскармливание.
Если ребенок не получает материнского молока, его иммунитет формируется в разы медленнее (данные европейских исследований). Это неблагоприятный сценарий становления организма ребенка.
Однако искусственные смеси просты в приготовлении, доступны, что делает их якобы достойной заменой естественному молоку. Это не так. Всеми силами искусственного вскармливания нужно избегать.
Перечень факторов, снижающих иммунитет неполный. Его можно продолжать и дальше.
Как инфекция проникает в организм?
pneumoniae.net
золотистый, у рбенка и взрослого, лечение, симптомы,
Что делать, если диагностирован стафилококк в горле? Группа стафилококков делится на несколько видов: сапрофитный, эпидермальный и золотистый. Все эти виды являются патогенными и вызывают гнойно-воспалительные процессы. Наибольшую опасность представляет наличие золотистого стафилококка в горле. Несмотря на такое привлекательное название — а назван он так из-за своего цвета, стафилококк, попадая в горло, становится провокатором многих серьезных заболеваний. К ним относятся: пневмония, гайморит, сепсис, менингит и другие. Этот микроб может поселиться в любом месте: в носу, на слизистой глаз, руках.

Но чаще всего он обитает в горле. Заболевание стрептококком встречаются в большинстве своем у детей, но взрослые тоже часто подвержены поражению им. У детей он проявляется чаще, потому что иммунитет ребенка не сформирован и может давать сбои.
Кое-что о стафилококках
Опасные бактерии. Стафилококк имеет возможность проникать через слой эпидермиса и вызвать воспалительные и аллергические реакции. Содержит в себе фермент, который разрушает клетки кожи. Устойчив к антибиотикам, быстро привыкает к ним и перестает реагировать на разрушительные способности лекарства.
Помимо того, что наличие золотистого стафилококка в горле делает его устойчивым к антибиотикам, он может выдерживать высокую температуру до 150 градусов. Он не поддается высушиванию, его не берут солевые растворы и перекись водорода. Частые ячмени и фурункулы также свидетельствуют о наличии стафилококка.
Попадая в кровь, бактерия может вызывать сепсис, то есть заражение крови. В крови этот микроб вырабатывает токсины, которые провоцируют различные заболевания. Это пневмония, менингит, мастит, остеомиелит. Вырабатывая энтеротоксин, стафилококк провоцирует расстройство желудка, рвоту, частый понос, боли в животе.
При хорошем иммунитете микроорганизмы никак себя не проявляют. Они обитают в слизистых человека: в носу, горле, глазах, во влагалище, кишечнике; но не дают о себе знать. Они могут объявиться только на фоне ослабленного организма. Многие врачи рекомендуют не беспокоиться по этому поводу, так как при крепком иммунитете эти микроорганизмы не могут причинить вреда. Поэтому следует в первую очередь укреплять иммунную систему.
Симптомы патологии
Попадая в горло, стафилококк начинает свою деятельность, принося человеку много проблем. К основным симптомам поражения горла стафилококком можно отнести:
- Красные припухшие миндалины.
- Слизистая горла покрывается гнойничками или же на ней присутствует белый налет.
- При глотании человек испытывает болевые ощущения.
- Повышается температура.
- Ощущается мышечная слабость.
Данные признаки характерны для проявлений стрептококковой ангины. Но разница при этом значительная. Стафилококковая инфекция в горле, в отличие от стрептококковой, плохо поддается лечению антибиотиками. Также она может продвигаться дальше вглубь организма и поражать внутренние органы и суставы.
Как заражаются стафилококком
Часто подхватить стафилококковую инфекцию можно в больничных учреждениях, роддомах и поликлиниках. Было уже сказано, что лечение его затруднительно, а если не лечить, то это может привести к плачевным последствиям. Стоит знать причины заражения этой инфекцией, чтобы в дальнейшем обезопасить себя.
Итак, пути заражения стафилококком:
- Воздушно-капельный: при чихании или кашле.
- Контактный: при пользовании предметами личной гигиены или посудой больного, при тесном контакте с инфицированным человеком.
- Употребление продуктов, зараженных стафилококком. Например, это может быть молоко больной коровы, яйца, мясо, кондитерские изделия.
- Через грудное вскармливание.
- Часто этим заболеваниям подвержены дети из-за постоянного облизывания пальчиков.
- Источниками проникновения стафилококка могут стать такие заболевания, как фарингит, кариес, бронхит, ларингит.
Лечение и диагностика золотистого стафилококка в горле
Чтобы диагностировать стафилококковую инфекцию в горле, следует провести некоторые анализы. Сдается посев из ротоглотки на выявление бактерий. После того как стафилококк был обнаружен, проводится следующий анализ на выявление чувствительности его к ряду антибиотиков. И уже исходя из результатов, можно назначать антибактериальную терапию. Если появится необходимость.
Как было уже описано, лечение золотистого стафилококка в горле не предусматривает применение антибиотиков. Стоит обратить внимание на укрепление иммунной системы. В этих целях назначается витаминотерапия, антистафилококковая плазма и иммуномодулирующие препараты. В качестве вспомогательной терапии при больном горле назначают частые полоскания с применением различных антисептиков, а также лекарственных трав: ромашки, череды, эвкалипта, листьев смородины.
В момент лечения противопоказаны какие-либо физиотерапевтические процедуры, это связано с тем, что они направлены на меры прогревания, что категорически запрещено при стафилококковой инфекции, так как воспаление перекинется дальше и увеличится.
Прежде чем назначить антибиотик, врач отправляет больного на анализ по выявлению чувствительности на тот или иной препарат.
Из медикаментозных препаратов назначаются:
- Полусинтетические и защитные пенициллины.
- Аминогликозиды.
- Тетрациклин.
- Офлоксацин.
- Клиндамицин.
- Препараты, повышающие иммунную систему, иммуноглобулины.
- Антисептики для полоскания.
- Витамины.
Особенно в детском возрасте применяется стафилококковый бактериофаг. Он является вирусом бактерий. Этот препарат действует на определенную группу микробов, не повреждая других. Является нормализатором микрофлоры в области скопления микробов. Не имеет побочных действий.
Часто стафилококковая инфекция протекает с симптомами ангины, поэтому и лечение прописывается соответствующее. В первую очередь назначается постельный режим, обильное питье и полоскания горла. Если возникает необходимость, то применяются, особенно в детском возрасте, жаропонижающие препараты и противовоспалительные средства. Стафилококк в горле у ребенка лечится теми же способами, что и у взрослых.
В случае если при сдаче анализов у здорового человека была выявлена стафилококковая палочка, то лечение антибиотиками и другими препаратами не проводится. Курс лечебной терапии назначают лишь работникам медицинских учреждений и людям, связанным с общепитом.
Если женщина планирует беременность, то ей тоже необходимо сдать анализ на присутствие возбудителя в крови. Нелишним будет, если и предполагаемый будущий отец ребенка тоже пройдет эту процедуру.
Народные средства лечения
Народные методы играют непоследнюю роль в лечении горла при стафилококковой инфекции. Рекомендуется каждый день есть черную смородину и абрикосы — они помогают в борьбе с этим микробом.
Вот еще некоторые способы победить инфекцию:
- Отвар эхинацеи и лопуха. Смешать в равных пропорциях корни этих растений, после чего взять 2 чайные ложки смеси и залить 400 гр горячей воды. Поставить на медленный огонь и немного поварить. Принимать отвар следует 3 раза в день по 1 стакану.
- Настой шиповника. Две горсти плодов насыпать в термос и залить кипятком, оставить, не трогая, на 10 часов. Принимать нужно по полстакана 2 раза в день.
- Отвары для полоскания. Следует смешать в одинаковом количестве шишки хмеля, душистую мяту, кипрей, корень аира и семена укропа. Взять 1 столовую ложку средства и залить 1 литром кипятка, слить смесь в термос и оставить на 7-8 часов. После этого делать полоскания и принимать по 100 мл.
Профилактические мероприятия
Так как стафилококк может передаваться воздушно-капельным и бытовым путем и в основном он проявляется на фоне пониженного иммунитета, важно следить за гигиеной тела, вести здоровый образ жизни и укреплять иммунитет.
Если возникает необходимость приема антибиотиков, то назначать их должен только врач. Контролируйте качество употребляемой пищи, не ешьте испорченные и просроченные продукты. Особенно это касается молочных изделий, мяса, яиц. Храните скоропортящиеся продукты в холодильнике.
Если у вас маленький ребенок, то стоит знать, что более всего подвержены этому заболеванию именно маленькие дети, по той причине, что детская иммунная система до конца не сформирована. И еще малыши так любят пробовать все на вкус, а это прямой путь заразиться данной инфекцией.
Укрепляйте в первую очередь детский организм, подбирайте правильную и нужную пищу, закаляйте ребенка, если возникает необходимость, давайте малышу витамины. В современное время была разработана вакцина против стафилококкового анатоксина, она делается маленьким детям, по возможности стоит ее сделать. Если имеются подозрения на стафилококковую инфекцию в горле ребенка, незамедлительно сообщите об этом педиатру.
gorlozdorovo.ru
Золотистый стафилококк в горле: симптомы, лечение бактериофагом, фото
В горле каждого человека живет золотистый стафилококк. Он относится к условно-патогенной микрофлоре. Это значит, что при отсутствии негативных факторов не причиняет вред организму. Но как только человек сталкивается со сниженным иммунитетом или переохлаждением, стафилококк начинает активно размножаться.
Что такое золотистый стафилококк?
 Это шарообразная бактерия, которая способна быть в воздухе. Свое название «золотистый» приобрел из-за золотистого свечения, которое появляется при посеве в питательную среду. По своей форме стафилококк под микроскопом похож на гроздь винограда.
Это шарообразная бактерия, которая способна быть в воздухе. Свое название «золотистый» приобрел из-за золотистого свечения, которое появляется при посеве в питательную среду. По своей форме стафилококк под микроскопом похож на гроздь винограда.
Впервые бактерия была обнаружена в 1800 году в Шотландском городе Абердине в гное абсцессов. Она является возбудителем многих инфекционных заболеваний. Стафилококк:
- Самый патогенный для человеческого организма.
- Устойчив к неблагоприятным факторам.
- Хорошо переносит нагрев и воздействие перекисью водорода.
- Способен находиться в потовых железах человека.
Как происходит заражение
Чаще всего заражение происходит в больницах при проведении внутривенных процедур, например, при использовании катетеров. Проникнуть может и через продукты. Хорошей средой для размножения является молоко, торты, консервы.
У взрослых заражение может происходить и при интимной близости с инфицированным человеком. Через слизистые бактерия проникает в мочеполовую систему.Обитают золотистые стафилококки и на ручках домов, мебели.
Как происходит заражение золотистым стафилококком, смотрите в нашем видео:
Симптомы
Симптоматика зависит от того, какое именно заболевание возникло на фоне заражения золотистым стафилококком. Если речь идет о тонзиллите, то температура тела повышается до 40 градусов.
В 50% случаев при размножении патогенной микрофлоры начинается фарингит. Для него характерным являются:
- осиплость голоса,
- повышение утомляемости и общего недомогания,
- увеличение температуры тела.
Может наблюдаться скопление слизи на задней стенке и повышение температуры тела.
При ларингите к болезненным ощущениям в горле часто присоединяется развитие трахеита и появление гнойного отделяемого. Изменяется тембр, высота и сила голоса. Иногда это доходит до полной его потери. Во время откашливания происходит отделение мокроты.
На фото горло, пораженное стафилококком
Причины
Избавиться от стафилококка в горле полностью можно, но он опять появится. Есть определенное количество бактерий, присутствие которых считается нормой. Но при появлении провоцирующих факторов происходит резкое увеличение микрофлоры. К ним относится:
- недостаток витаминов в организме ребенка или взрослого,
- снижение иммунных сил организма,
- развитие кариеса,
- наличие хронического бронхита,
- инфекции придаточных пазух носа.
Диагностика инфекции в горле
Окончательный диагноз ставится только после проведения исследований.
Окончательный диагноз ставится только после проведения исследований.
Одним из эффективных является микробиологический способ, когда делается мазок из горла. Бактерии помещаются в питательную среду.
Через 18-24 часа золотистый стафилококк начинается образовывать колонии.
Если результат нужно получить быстро, применяется коагулазный тест, который выявляет наличие инфекции в организме быстрее.
Результат готов через 4 часа, но при отрицательном ответе исследование продлевается.
Если говорить о серологическом способе, то используются наборы из 23 бактериофагов. Один штамм убивает 1 фаг или группу. Этот способ в последние годы используется только в качестве дополнительного, поскольку не обладает высокой точностью.
Методы лечения
Главная цель лечение – повышение иммунитета и сопротивляемости организма. Обычно используются медикаментозные методы, которые дополняются народными средствами.
Как избавиться от золотистого стафилококка:
Медикаментозно
Простимулировать иммунную систему на естественное сопротивление легко с помощью иммуностимуляторов. Считается, если концентрация стафилококка слишком повышена, это свидетельствует об угнетении защитных сил организма.
Иммуномодуляторы содержат деактивированные фрагменты бактерий. Благодаря этому организм запускает усиленную выработку интерферона, которая и приводит к улучшению иммунного ответа. Такие лекарства обычно используются местного действия. Популярными являются Имудон и ИРС-19.
В некоторых случаях не обойтись без антибактериальных препаратов. Стафилококки устойчивы к некоторым таблеткам, но остается чувствительной к Азитромицину, Цефриаксону и некоторым другим. В совокупности с такими препаратами назначаются полоскания настойкой календулы или Хлорфиллиптом. Для восстановления иммунитета могут использоваться растительные адаптогены, народные средства, минеральные комплексы.
Популярные препараты для лечения стафилококка
Народными средствами
Можно проводить лечение свежими ягодами. В течение 10 дней нужно съедать большое количество абрикосов и черной смородины. После этого запрещается есть и пить. Полезными свойствами обладает отвар шиповника. Он пагубно воздействует на стафилококк и укрепляет собственные силы организма. Достаточно пить по 100 мл дважды в день перед едой.
Если хотите сразу провести профилактику бронхита и пневмонии, то используйте стакан эхинацеи и лопуха. Сделайте из них отвар из двух чайных ложек смеси и 800 мл воды.
Лечение с использованием медикаментов и методов народной медицины следует сочетать с диетой. Нужно максимально уменьшить количество углеводов, особенно от фастфуда.
Чем опасен
Золотистый стафилококк часто становится причиной развития самых тяжелых осложнений. У новорожденных, например, может привести к развитию пузырчатки. Патогенные клетки проникают в мягкие ткани, поэтому на слизистой появляются болезнетворные язвы и эрозии. Со временем ткани могут загнить, а их лечение проводится только хирургическим путем.
Золотистый стафилококк продуцирует ядовит фермент, легко проникающий в системный кровоток. Это приводит к появлению признаком отравления. Если уровень токсиннейтрализующих антител низкий, может возникнуть токсический шок. Вероятность его появления увеличивается у женщин в период менструации, при перенесенных хирургических операциях и у детей.
Патогенная микрофлора легко преодолевает межтканевые барьеры. Поэтому при наличии стафилококка в горле может перейти инфекция в придаточные пазухи и среднее ухо. Если не лечить, то это приводит к внутричерепным инфекциям.
Отзывы доктора Комаровского о лечении стафилококковой инфекции:
Профилактика
Вероятность заболеть снизиться, если питание будет сбалансированным и правильным, содержать необходимые витамины. Нужно тщательно мыть руки перед едой и полноценно отдыхать.
Часто переход микроба в патогенную флору происходит на фоне простуды, особое внимание уделяется профилактическим мерам в период эпидемий. Можно принимать в целях профилактики противовирусные препараты дважды в год.
Прогноз
При правильном лечении прогноз благоприятный. При частых рецидивах рекомендована консультация иммунолога и проведение исследования на определение иммунного статуса. Золотистый стафилококк является проблемой в семьях, где есть маленькие дети. Он может стать причиной развития хронических болезней, поэтому только лечение, основанное на проведении анализов, поможет сохранить здоровье семьи.
gidmed.com
признаки, чем и как лечить у взрослого
Стафилококк в горле присутствует практически у всех людей, поскольку бактерия входит в группу условно-патогенной микрофлоры. При наличии благоприятных факторов микробы начинают активно размножаться, в организме возникают инфекционно-воспалительные процессы.

СодержаниеПоказать
Причины заражения стафилококком
загрузка…
В слизистой носа и в зеве каждого пятого человека обитает золотистый стафилококк (aureus), который считается одной из наиболее опасных бактерий, поскольку микроб устойчив ко многим антибиотикам, антисептикам. Как выглядят возбудители инфекционных патологий, можно рассмотреть на фото.

Долгое время ауреус никак себя не проявляет, но во время гриппа, ОРВИ, при ослаблении иммунитета, на фоне частых стрессов и переохлаждения, кариеса стафилококк начинает активно расти и размножаться, пусковым механизмом может послужить и длительный прием антибактериальных препаратов.
Как передается стафилококк:
- При контакте с предметами общего пользования – контактный путь инфицирования довольно распространен в детских садах и школах. Стафилококки с кожи рук проникают на слизистую носа или рта при несоблюдении правил гигиены.
- Воздушно-капельный путь передачи – человек вдыхает воздух, пыль в котором присутствуют стафилококки, приникают бактерии во внешнюю среду во время кашля, разговора, чихания, сохраняют жизнеспособность до 6 месяцев.
- Алиментарный путь – стафилококк проникает в организм через грязные или неправильно термически обработанные продукты питания.
- От матери к ребенку внутри утробы, при прохождении по родовым путям, через грудное молоко – для маленьких детей стафилококк очень опасен.
- Внутрибольничное заражение стафилококком – через грязные медицинские инструменты.
Но чаще всего стафилококковые инфекции возникают при переходе бессимптомного носительства бактерий в стадию заболевание.
При активном росте золотистого стафилококка часто увеличивается и количество стрептококков вириданс, которые обитают в ротовой полости, крепясь к зубам и деснам.
Основные симптомы инфекции
Золотистый стафилококк становится причиной развития тонзиллита, фарингита, ларингита, у взрослых людей среднего возраста патологии диагностируют редко, чаще всего от бактерий страдают дети, беременные, пожилые люди.
| Заболевание | Основные симптомы |
| Стафилококковый тонзиллит | Внезапное повышение температуры до 39.5 и более градусов; отечность, покраснение миндалин и глотки; на гландах появляются гнойные образования бледно-желтого цвета, которые легко удаляются. Признаки сильной интоксикации – слабость, повышенное слезотечение, мышечная и суставная боль, приступы головокружения при смене положения тела, озноб. Выраженный дискомфорт в горле, боль отдает в височную зону, шею, ухо, из-за неприятных ощущений при глотании у человека снижается аппетит; увеличиваются шейные лимфоузлы. |
| Стафилококковый фарингит (редкое заболевание, диагностируют примерно у 5% пациентов) | Сильное воспаление слизистой горла, что проявляется в слущивании эпителия, отечности и покраснении; на задней стенке глотки начинает скапливаться вязкая слизь. Сухой кашель из-за сильного першения в горле; боль при глотании, осиплость голоса; повышение температуры, слабость. |
| Стафилококковый ларингит (часто развивается одновременно с трахеитом) | Очаг воспаления находится в слизистой оболочки гортани, трахеях. На начальном этапе развития заболевания появляется сухой кашель, который постепенно становится влажным, в мокроте присутствуют вкрапления гноя. Боль в горле, которая усиливается при разговоре, глотании; сухость, царапанье, першение в горле. Снижение тембра голоса, иногда развивается афония. Повышение температуры до субфебрильных отметок. |
Стафилококковые инфекции без надлежащего лечения быстро прогрессируют, патогенные бактерии проникают в кровь, внутренние органы – развиваются пневмония, сепсис, менингит, остеомиелит, миокардит.
Методы диагностики
Что говорят врачи о паразитах
Доктор медицинских наук, профессор Гандельман Г. Ш.:
Занимаюсь обнаружением и лечением паразитов уже много лет. С уверенностью могу сказать, что паразитами заражены практически все. Просто большинство из них крайне трудно обнаружимы. Они могут быть где угодно — в крови, кишечнике, легких, сердце, мозге. Паразиты в буквальном смысле пожирают вас изнутри, заодно отравляя организм. В итоге, появляются многочисленные проблемы со здоровьем, сокращающие жизнь на 15-25 лет.
Основная ошибка — затягивание! Чем раньше начать выводить паразитов, тем лучше. Если же говорить о лекарствах, то тут всё проблематично. На сегодняшний день существует только один действительно эффективный антипаразитный комплекс, это Toximin. Он уничтожает и выметает из организма всех известных паразитов — от головного мозга и сердца до печени и кишечника. На такое не способен больше ни один из существующих сегодня препаратов.
В рамках Федеральной программы, при подаче заявки до 12 октября. (включительно) каждый житель РФ и СНГ может получить одну упаковку Toximin БЕСПЛАТНО!
Выявить возбудителей инфекционной патологии можно при помощи бакпосева мазка, его берут из зева, носа, гнойных язв в горле.

Поскольку лечение проводят при помощи антибиотиков, дополнительно проводят пробу на чувствительность бактерий к разным группам этих препаратов. Если стафилококк обнаружен у грудничка, то маме обязательно нужно сделать анализ молока.
Методы исследования мазка на стафилококк:
- Микроскопический – полученный биоматериал окрашивают по Грамму, различные стафилококки после этого приобретают синий оттенок.
- Культуральный – содержимое мазка помещают в специальную питательную среду, бактерии проращивают. Для получения результатов анализов потребуется несколько дней, но метод позволяет выявить конкретный вид стафилококка.
Чтобы результаты диагностики на стафилококк были максимально достоверными, необходимо за несколько дней до обследования перестать полоскать горло, не пользоваться антибактериальными спреями. Мазок следует сдавать на голодный желудок, нельзя ничего пить, чистить зубы.
Норма золотистого стафилококка в анализах
В идеале анализы должны показать полное отсутствие золотистого стафилококка в организме. Но поскольку такая ситуация бывает редко, врачи установили предельно допустимые границы.
Значение показателей золотистого стафилококка:
- 10 в 0–10 в 3 степени – норма;
- 10 в 4–10 в 5 степени – относительная норма, необходимо провести терапию иммуномодулирующими препаратами;
- 10 в 5 степени и выше – активный рост бактерий, требуется лечение антибиотиками.
Для постановки диагноза важнее не столько количество патогенных микроорганизмов в исследуемом биоматериале, сколько скорость роста стафилококков. Поэтому анализы необходимо сдавать несколько раз, при заметном увеличении числа бактерий, незамедлительно назначают антибиотики.
Лечение заболеваний горла
загрузка…
Для устранения стафилококка применяют антибактериальные препараты, обязательно назначают иммуномодулирующие средства, витаминные комплексы. Усилить действие медикаментозной терапии помогут рецепты народной медицины.
Антибиотики от стафилококка
Основа медикаментозного лечения стафилококковых инфекций – антибактериальная терапия, применяют лекарства в таблетированной форме, в виде растворов для полоскания, при тяжелых формах заболевания препараты вводят инъекционным путем.
загрузка…
Если применять антибиотики нельзя или бактерии обладают стойким иммунитетом к препаратам, назначают специальные стафилококковые бактериофаги.
При наличии высыпаний в ротовой полости, перед началом терапии их вскрывают, обрабатывают антисептическим раствором.
Чем лечить стафилококк:
- пенициллины – Амоксициллин, Амоксиклав, детям назначают Флемоклав солютаб;
- цефалоспорины последнего поколения – Зиннат, Цефтриаксон;
- макролиды – Азитромицин;
- аминогликозиды – Неомицин, Канамицин.
Минимальная продолжительность антибактериальной терапии при стафилококке – пять дней, в среднем составляет 10–14 суток, даже при значительном улучшении самочувствия прерывать курс нельзя.
Помимо приема таблеток, при стафилококке необходимо не менее четырех раз в сутки обрабатывать и полоскать горло растворами и спреями от стафилококка – Хлорофиллипт, Мирамистин, перекись водорода, марганцовка.
Ускорить процесс регенерации в тканях воспаленных миндалин помогут масляные препараты – Аекол, Винилин. Для борьбы с воспалительным процессом можно применять таблетки для рассасывания – Септолете, Себидин.
При диагностировании стафилококка у беременных антибиотики назначают в крайних случаях. Женщинам назначают полоскания раствором Хлорофиллипта, орошение слизистой спреем ИРС-19. Если через 2 недели после повторной сдачи анализов количество бактерий не уменьшится, терапию дополняют сильнодействующими препаратами.
Эффективность лечения народными средствами
загрузка…
Нетрадиционные методы лечения стафилококка направлены на укрепление иммунитета, устранение воспалительного процесса, но применять их необходимо только в комплексе с лекарственными препаратами.

Как избавиться от стафилококка при помощи нетрадиционной медицины:
- Измельчить корни эхинацеи и лопуха, смещать их в равных пропорциях. Заварить 800 мл кипятка 2 ч. л. сырья, смесь довести на маленьком огне до кипения. Принимать по 200 мл лекарства 3 раза в день.
- Смешать по 1 ст. л. березовых почек, травы тысячелистника, тимьяна, череды и багульника. Сбор залить 450 мл кипятка, оставить в закрытой посуде на 2 часа. Пить по 120 мл 4 раза в день.
- Каждые 3–4 часа необходимо полоскать горло раствором прополиса – в 220 мл теплой воды растворить 5 мл аптечной настойки.
- Несколько раз в день в течение получаса рассасывать по 5 г меда.
Лечение стафилококка – длительный и трудоемкий процесс.
На время терапии следует исключить из рациона острую, соленую, пряную, жирную и жареную пищу – вредная еда не только негативно влияет на иммунитет, но и раздражает слизистую. В меню должно быть достаточное количество кисломолочной продукции, фруктов и овощей с высоким содержанием аскорбиновой кислоты.
Для ускорения процесса выздоровления при стафилококке в горле необходимо каждый день съедать по 100 г ягод черной смородины и 0,5 кг абрикосов.
Профилактика заражения
Чтобы избежать заражения золотистым стафилококком, необходимо соблюдать простые правила профилактики, всячески укреплять защитные функции организма.
Как предотвратить инфицирование стафилококком:
- отказаться от пагубных пристрастий, особенно от курения;
- больше времени проводить на свежем воздухе, регулярно заниматься спортом, не забывать о закаливающих процедурах, контролировать вес;
- правильно и сбалансировано питаться;
- поддерживать в помещении оптимальную температуру и влажность, проветривать комнату несколько раза в день;
- тщательно мыть все овощи и фрукты, мясо и рыбу подвергать тщательной термической обработке, не пить грязную воду;
- соблюдать гигиенические нормы, чаще мыть руки, стараться лишний раз не прикасаться к лицу.
Чтобы избежать инфицирования, необходимо избегать контактов с людьми, у которых присутствуют все признаки заболевания – кашель, насморк, осипший голос, слезотечение.
Заражение стафилококком не всегда означает проблему. Подробнее об этом расскажет доктор Комаровский:
Золотистый стафилококк в горле становится причиной развития ангины, ларингита, фарингита. Если не начать лечение вовремя, инфекция с кровотоком разнесется по всему организму, что чревато возникновением опасных и даже смертельных заболеваний.
Если заражение все же случилось, его лучше распознать как можно раньше:
Своевременная диагностика, правильный выбор антибиотиков поможет избежать осложнений, а при соблюдении простых профилактических мер можно свести риск заражения к минимуму.
загрузка…
otparazitoff.ru